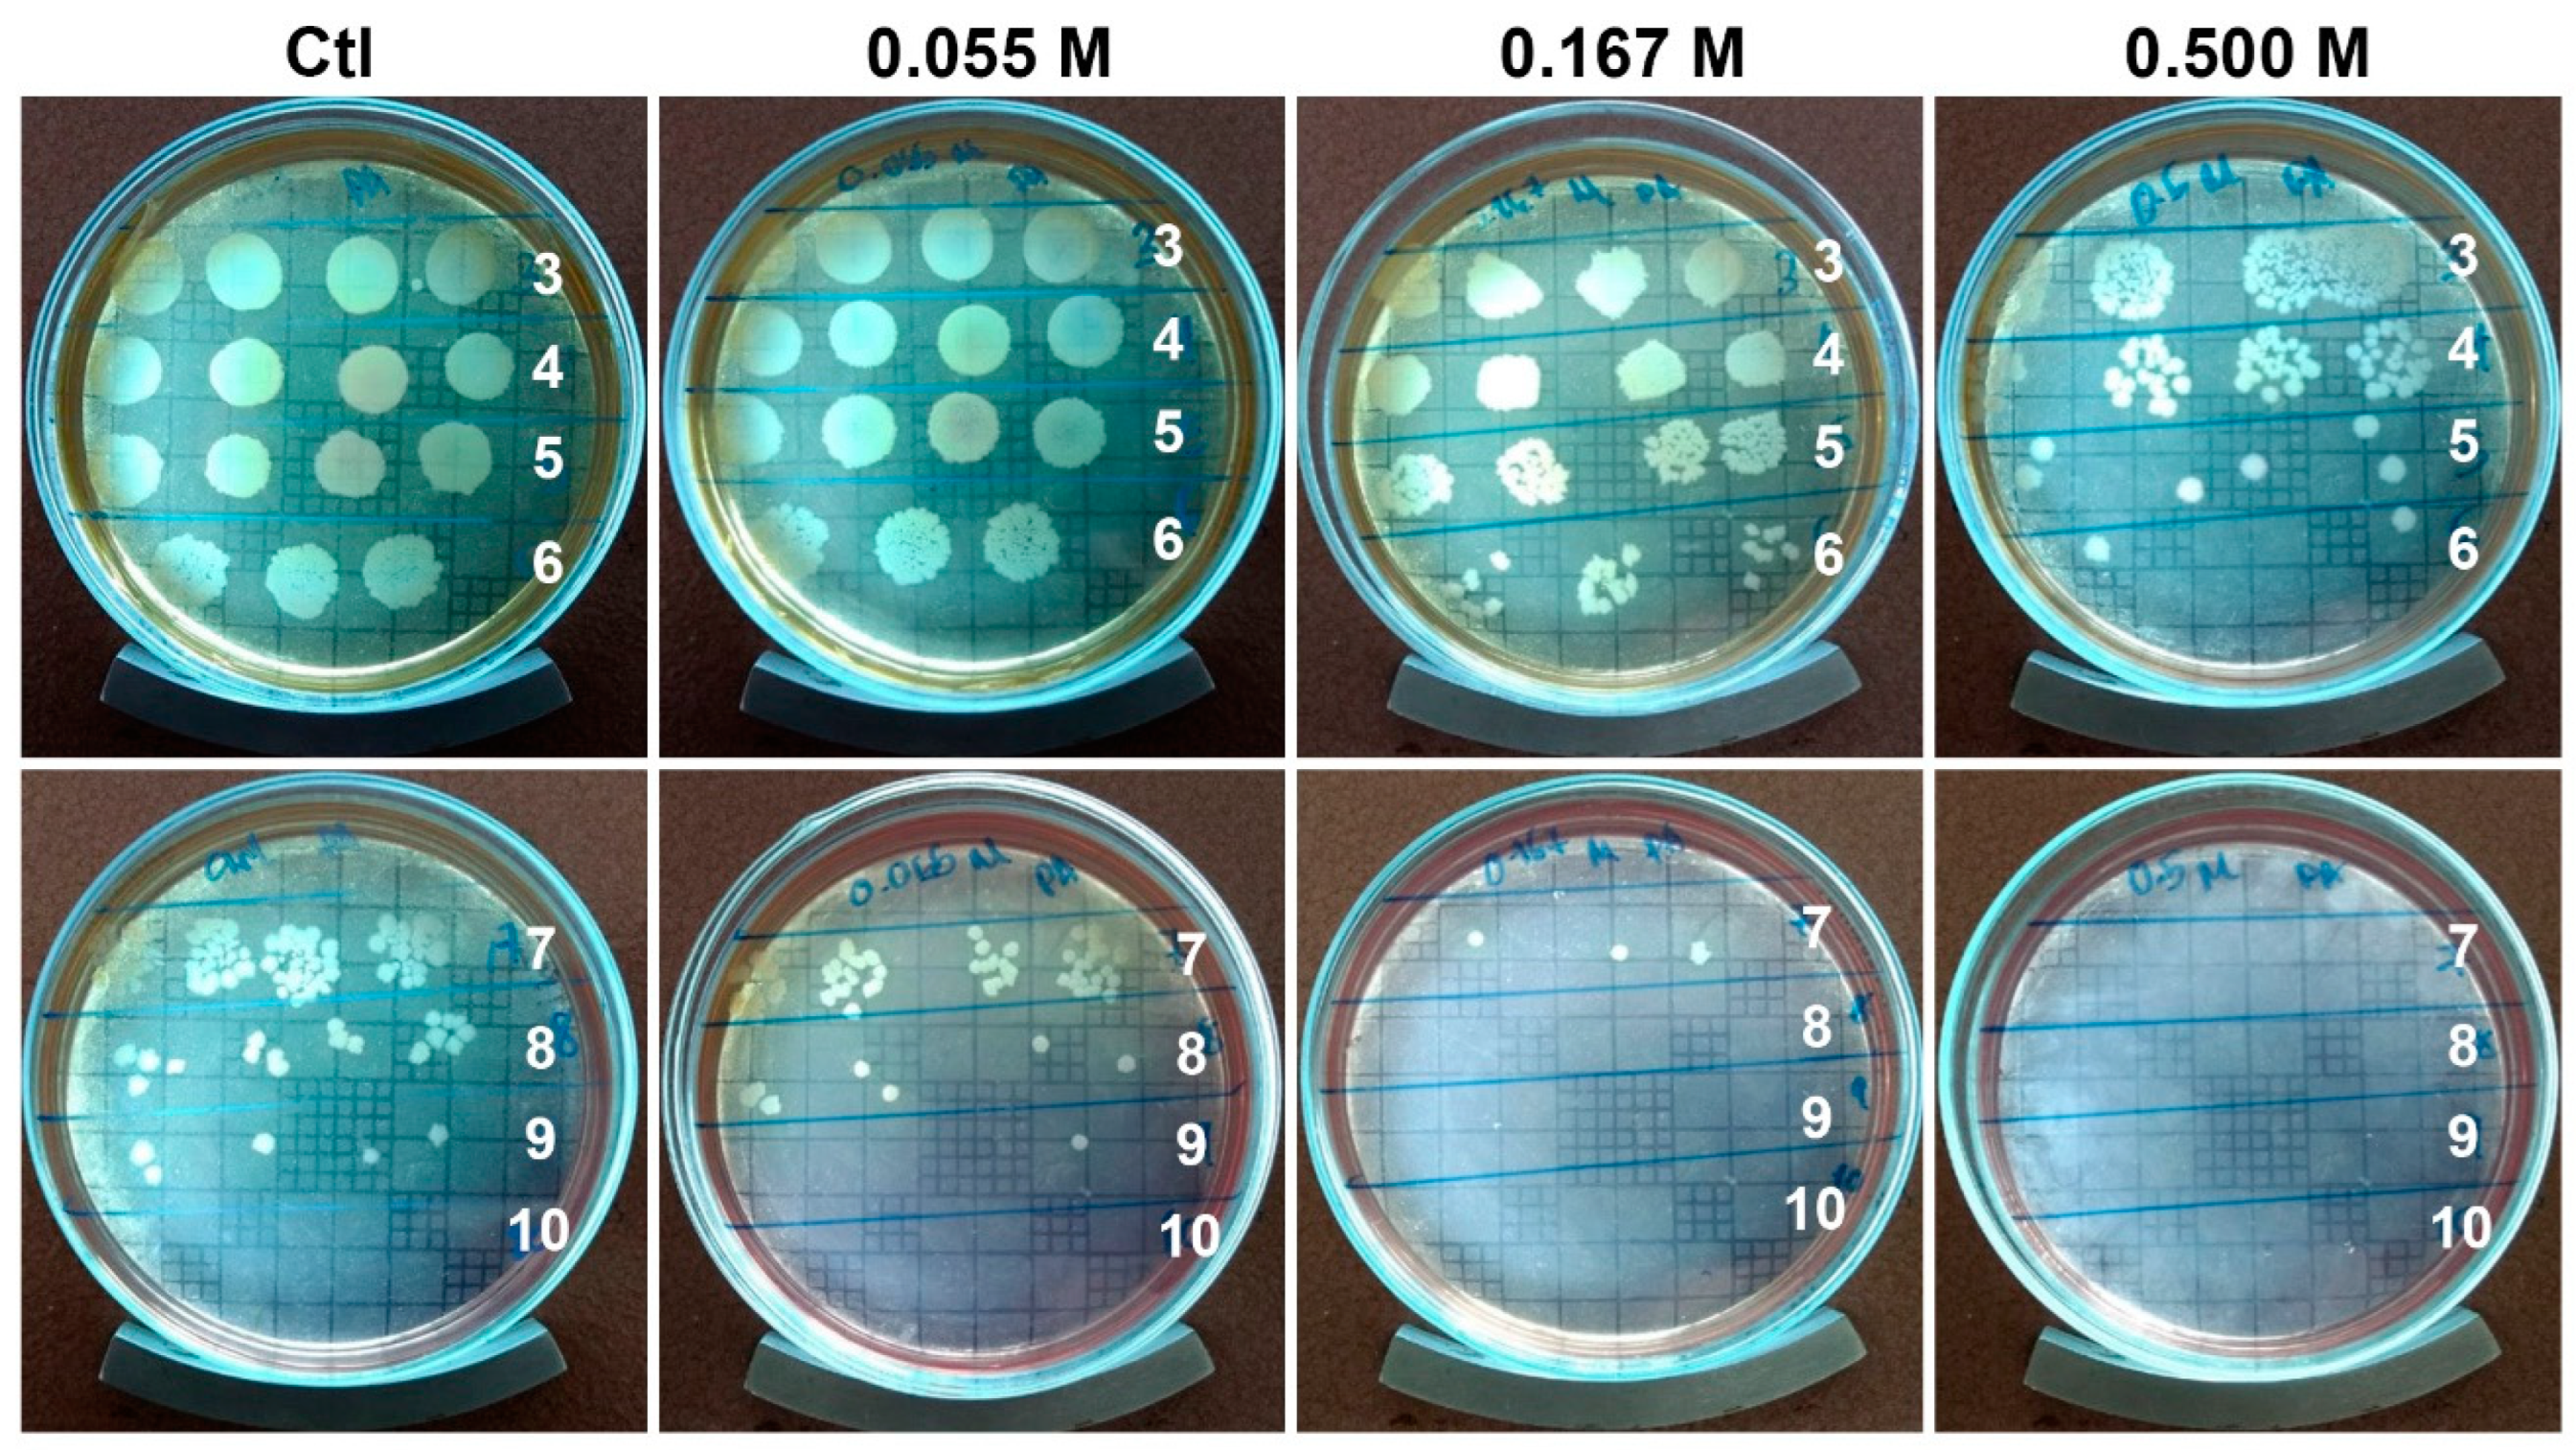
Ijms 23 13910 g006

Development of Radiosterilized Porcine Skin Electrosprayed with Silver Nanoparticles Prevents Infections in Deep Burns
Abstract
1. Introduction
2. Results and Discussion
2.1. AgNPs Characterization
2.2. Radiosterilized Porcine Skin Covered with Silver Nanoparticles by Electrospray
2.3. Antibiofilm Activity
2.4. Viability of Dermal Fibroblast
3. Methods
3.1. Synthesis and Characterization of AgNPs
3.2. Covering Radiosterilized Porcine Skin with AgNPs Using Electrospray
3.3. Characterization of Radiosterilized Porcine Skin Covered with AgNPs
3.4. Bacterial Strain Used in This Study
3.5. Evaluation of the Antibiofilm Activity
3.6. Isolation of Dermal Fibroblast
3.7. Viability Assay of Dermal Fibroblast
3.8. Statistical Analysis
4. Conclusions
Author Contributions
Funding
Institutional Review Board Statement
Informed Consent Statement
Data Availability Statement
Acknowledgments
Conflicts of Interest
References
- Naves, L.B.; Dhand, C.; Almeida, L.; Rajamani, L.; Ramakrishna, S. In Vitro Skin Models and Tissue Engineering Protocols for Skin Graft Applications. Essays Biochem. 2016, 60, 357–369. [Google Scholar] [CrossRef]
- Wang, Y.; Beekman, J.; Hew, J.; Jackson, S.; Issler-Fisher, A.C.; Parungao, R.; Lajevardi, S.S.; Li, Z.; Maitz, P.K.M. Burn Injury: Challenges and Advances in Burn Wound Healing, Infection, Pain and Scarring. Adv. Drug Deliv. Rev. 2018, 123, 3–17. [Google Scholar] [CrossRef] [PubMed]
- Koyro, K.I.; Bingoel, A.S.; Bucher, F.; Vogt, P.M. Burn Guidelines—An International Comparison. Eur. Burn J. 2021, 2, 125–139. [Google Scholar] [CrossRef]
- Maslova, E.; Eisaiankhongi, L.; Sjöberg, F.; McCarthy, R.R. Burns and Biofilms: Priority Pathogens and in Vivo Models. NPJ Biofilms Microbiomes 2021, 7, 73. [Google Scholar] [CrossRef]
- Ghanbarzadeh Corehtash, Z.; Khorshidi, A.; Firoozeh, F.; Akbari, H.; Mahmoudi Aznaveh, A. Biofilm Formation and Virulence Factors Among Pseudomonas Aeruginosa Isolated From Burn Patients. Jundishapur J. Microbiol. 2015, 8, e22345. [Google Scholar] [CrossRef]
- Al-Wrafy, F.; Brzozowska, E.; Górska, S.; Gamian, A. Pathogenic Factors of Pseudomonas Aeruginosa—The Role of Biofilm in Pathogenicity and as a Target for Phage Therapy. Postep. Hig. I Med. Dosw. 2017, 71, 78–91. [Google Scholar] [CrossRef]
- Stewart, P.S.; Franklin, M.J. Physiological Heterogeneity in Biofilms. Nat. Rev. Microbiol. 2008, 6, 199–210. [Google Scholar] [CrossRef] [PubMed]
- Salisbury, A.-M.; Woo, K.; Sarkar, S.; Schultz, G.; Malone, M.; Mayer, D.O.; Percival, S.L. Tolerance of Biofilms to Antimicrobials and Significance to Antibiotic Resistance in Wounds. Surg. Technol. Int. 2018, 33, 59–66. [Google Scholar] [PubMed]
- Stewart, P.S. Antimicrobial Tolerance in Biofilms. Microbiol. Spectr. 2015, 3, 3. [Google Scholar] [CrossRef]
- Markowska, K.; Grudniak, A.M.; Wolska, K.I. Silver Nanoparticles as an Alternative Strategy against Bacterial Biofilms. Acta Biochim. Pol. 2013, 60, 523–530. [Google Scholar] [CrossRef]
- Chen, X.; Jiang, J.; Ren, Z.; Li, J.; Zhang, H.; Xu, J.; Du, H. Antibacterial activity of silver nanoparticles against multiple drug resistant strains. Wei Sheng Wu Xue Bao 2017, 57, 539–549. [Google Scholar]
- Pérez-Díaz, M.A.; Boegli, L.; James, G.; Velasquillo, C.; Sánchez-Sánchez, R.; Martínez-Martínez, R.-E.; Martínez-Castañón, G.A.; Martinez-Gutierrez, F. Silver Nanoparticles with Antimicrobial Activities against Streptococcus Mutans and Their Cytotoxic Effect. Mater. Sci. Eng. C 2015, 55, 360–366. [Google Scholar] [CrossRef]
- Durán, N.; Durán, M.; de Jesus, M.B.; Seabra, A.B.; Fávaro, W.J.; Nakazato, G. Silver Nanoparticles: A New View on Mechanistic Aspects on Antimicrobial Activity. Nanomedicine 2016, 12, 789–799. [Google Scholar] [CrossRef]
- Slavin, Y.N.; Asnis, J.; Häfeli, U.O.; Bach, H. Metal Nanoparticles: Understanding the Mechanisms behind Antibacterial Activity. J. Nanobiotechnol. 2017, 15, 65. [Google Scholar] [CrossRef]
- Behera, S.S.; Das, U.; Kumar, A.; Bissoyi, A.; Singh, A.K. Chitosan/TiO2 Composite Membrane Improves Proliferation and Survival of L929 Fibroblast Cells: Application in Wound Dressing and Skin Regeneration. Int. J. Biol. Macromol. 2017, 98, 329–340. [Google Scholar] [CrossRef]
- Wurzer, P.; Keil, H.; Branski, L.K.; Parvizi, D.; Clayton, R.P.; Finnerty, C.C.; Herndon, D.N.; Kamolz, L.P. The Use of Skin Substitutes and Burn Care-a Survey. J. Surg. Res. 2016, 201, 293–298. [Google Scholar] [CrossRef]
- Gillenwater, J.; Garner, W. Acute Fluid Management of Large Burns: Pathophysiology, Monitoring, and Resuscitation. Clin. Plast. Surg. 2017, 44, 495–503. [Google Scholar] [CrossRef]
- Shahrokhi, S.; Arno, A.; Jeschke, M.G. The Use of Dermal Substitutes in Burn Surgery: Acute Phase. Wound Repair Regen. 2014, 22, 14–22. [Google Scholar] [CrossRef] [PubMed]
- Debeer, S.; Le Luduec, J.-B.; Kaiserlian, D.; Laurent, P.; Nicolas, J.-F.; Dubois, B.; Kanitakis, J. Comparative Histology and Immunohistochemistry of Porcine versus Human Skin. Eur. J. Derm. 2013, 23, 456–466. [Google Scholar] [CrossRef] [PubMed]
- El-Naggar, M.E.; Shaheen, T.I.; Fouda, M.M.G.; Hebeish, A.A. Eco-Friendly Microwave-Assisted Green and Rapid Synthesis of Well-Stabilized Gold and Core-Shell Silver-Gold Nanoparticles. Carbohydr Polym 2016, 136, 1128–1136. [Google Scholar] [CrossRef] [PubMed]
- Brollo, M.E.F.; Veintemillas-Verdaguer, S.; Salván, C.M.; Morales, M.D.P. Key Parameters on the Microwave Assisted Synthesis of Magnetic Nanoparticles for MRI Contrast Agents. Contrast Media Mol. Imaging 2017, 2017, 8902424. [Google Scholar] [CrossRef]
- Jayaraman, P.; Gandhimathi, C.; Venugopal, J.R.; Becker, D.L.; Ramakrishna, S.; Srinivasan, D.K. Controlled Release of Drugs in Electrosprayed Nanoparticles for Bone Tissue Engineering. Adv. Drug Deliv. Rev. 2015, 94, 77–95. [Google Scholar] [CrossRef]
- Wilhelm, O.; Mädler, L.; Pratsinis, S.E. Electrospray Evaporation and Deposition. J. Aerosol Sci. 2003, 34, 815–836. [Google Scholar] [CrossRef]
- Zoroddu, M.A.; Medici, S.; Ledda, A.; Nurchi, V.M.; Lachowicz, J.I.; Peana, M. Toxicity of Nanoparticles. Curr. Med. Chem. 2014, 21, 3837–3853. [Google Scholar] [CrossRef]
- Lara, H.H.; Ayala-Núñez, N.V.; del Carmen Ixtepan Turrent, L.; Rodríguez Padilla, C. Bactericidal Effect of Silver Nanoparticles against Multidrug-Resistant Bacteria. World J. Microbiol. Biotechnol. 2010, 26, 615–621. [Google Scholar] [CrossRef]
- Lara, H.H.; Romero-Urbina, D.G.; Pierce, C.; Lopez-Ribot, J.L.; Arellano-Jiménez, M.J.; Jose-Yacaman, M. Effect of Silver Nanoparticles on Candida Albicans Biofilms: An Ultrastructural Study. J. Nanobiotechnol. 2015, 13, 91. [Google Scholar] [CrossRef] [PubMed]
- Horta-Fraijo, P.; Smolentseva, E.; Simakov, A.; José-Yacaman, M.; Acosta, B. Ag Nanoparticles in A4 Zeolite as Efficient Catalysts for the 4-Nitrophenol Reduction. Microporous Mesoporous Mater. 2021, 312, 110707. [Google Scholar] [CrossRef]
- Aitenneite, H.; Abboud, Y.; Tanane, O.; Solhy, A.; Sebti, S.; El Bouari, A. Rapid and Green Microwave-Assisted Synthesis of Silver Nanoparticles Using Aqueous Phoenix Dactylifera L. (Date Palm) Leaf Extract and Their Catalytic Activity for 4-Nitrophenol Reduction. J. Mater. Environ. Sci. 2016, 7, 2335–2339. [Google Scholar]
- Brown, N.A.; Zhu, Y.; German, G.K.; Yong, X.; Chiarot, P.R. Electrospray Deposit Structure of Nanoparticle Suspensions. J. Electrost. 2017, 90, 67–73. [Google Scholar] [CrossRef]
- Kavadiya, S.; Biswas, P. Electrospray Deposition of Biomolecules: Applications, Challenges, and Recommendations. J. Aerosol Sci. 2018, 125, 182–207. [Google Scholar] [CrossRef]
- Pérez-Díaz, M.A.; Silva-Bermudez, P.; Jiménez-López, B.; Martínez-López, V.; Melgarejo-Ramírez, Y.; Brena-Molina, A.; Ibarra, C.; Baeza, I.; Martínez-Pardo, M.E.; Reyes-Frías, M.L.; et al. Silver-Pig Skin Nanocomposites and Mesenchymal Stem Cells: Suitable Antibiofilm Cellular Dressings for Wound Healing. J. Nanobiotechnol. 2018, 16, 2. [Google Scholar] [CrossRef] [PubMed]
- Briggaman, R.A.; Wheeler, C.E. The Epidermal-Dermal Junction. J. Investig. Dermatol. 1975, 65, 71–84. [Google Scholar] [CrossRef] [PubMed]
- Palade, G.E.; Farquhar, M.G. A Special Fibril of the Dermis. J. Cell Biol. 1965, 27, 215–224. [Google Scholar] [CrossRef] [PubMed]
- Brody, I. The Ultrastructure of the Tonofibrils in the Keratinization Process of Normal Human Epidermis. J. Ultrastruct. Res. 1960, 4, 264–297. [Google Scholar] [CrossRef]
- Ross, R.; Bornstein, P. The Elastic Fiber: I. The Separation and Partial Characterization of Its Macromolecular Components. J. Cell Biol. 1969, 40, 366–381. [Google Scholar] [CrossRef]
- Zhang, Y.; Xu, J.; Chai, Y.; Zhang, J.; Hu, Z.; Zhou, H. Nano-Silver Modified Porcine Small Intestinal Submucosa for the Treatment of Infected Partial-Thickness Burn Wounds. Burns 2019, 45, 950–956. [Google Scholar] [CrossRef]
- Zulkifli, F.H.; Rani, N.A.M.; Shahitha, F. Carboxymethyl Cellulose Nanofibres Impregnated with Silver Nanoparticles for Tissue Engineering Applications. Mater. Today Proc. 2019, 16, 1715–1721. [Google Scholar] [CrossRef]
- Jiji, S.; Udhayakumar, S.; Maharajan, K.; Rose, C.; Muralidharan, C.; Kadirvelu, K. Bacterial Cellulose Matrix with in Situ Impregnation of Silver Nanoparticles via Catecholic Redox Chemistry for Third Degree Burn Wound Healing. Carbohydr. Polym. 2020, 245, 116573. [Google Scholar] [CrossRef]
- Srivastava, C.M.; Purwar, R.; Gupta, A.P. Enhanced Potential of Biomimetic, Silver Nanoparticles Functionalized Antheraea Mylitta (Tasar) Silk Fibroin Nanofibrous Mats for Skin Tissue Engineering. Int. J. Biol. Macromol. 2019, 130, 437–453. [Google Scholar] [CrossRef]
- Singh, P.; Pandit, S.; Garnæs, J.; Tunjic, S.; Mokkapati, V.R.; Sultan, A.; Thygesen, A.; Mackevica, A.; Mateiu, R.V.; Daugaard, A.E.; et al. Green Synthesis of Gold and Silver Nanoparticles from Cannabis Sativa (Industrial Hemp) and Their Capacity for Biofilm Inhibition. Int. J. Nanomed. 2018, 13, 3571–3591. [Google Scholar] [CrossRef]
- Stunova, A.; Vistejnova, L. Dermal Fibroblasts-A Heterogeneous Population with Regulatory Function in Wound Healing. Cytokine Growth Factor Rev. 2018, 39, 137–150. [Google Scholar] [CrossRef] [PubMed]
- Nešporová, K.; Pavlík, V.; Šafránková, B.; Vágnerová, H.; Odráška, P.; Žídek, O.; Císařová, N.; Skoroplyas, S.; Kubala, L.; Velebný, V. Effects of Wound Dressings Containing Silver on Skin and Immune Cells. Sci. Rep. 2020, 10, 15216. [Google Scholar] [CrossRef] [PubMed]
- Roshangar, L.; Soleimani Rad, J.; Kheirjou, R.; Reza Ranjkesh, M.; Ferdowsi Khosroshahi, A. Skin Burns: Review of Molecular Mechanisms and Therapeutic Approaches. Wounds 2019, 31, 308–315. [Google Scholar]
- Mohseni, M.; Shamloo, A.; Aghababaie, Z.; Afjoul, H.; Abdi, S.; Moravvej, H.; Vossoughi, M. A Comparative Study of Wound Dressings Loaded with Silver Sulfadiazine and Silver Nanoparticles: In Vitro and in Vivo Evaluation. Int. J. Pharm. 2019, 564, 350–358. [Google Scholar] [CrossRef]
- Wasef, L.G.; Shaheen, H.M.; El-Sayed, Y.S.; Shalaby, T.I.A.; Samak, D.H.; Abd El-Hack, M.E.; Al-Owaimer, A.; Saadeldin, I.M.; El-mleeh, A.; Ba-Awadh, H.; et al. Effects of Silver Nanoparticles on Burn Wound Healing in a Mouse Model. Biol. Trace Elem. Res. 2020, 193, 456–465. [Google Scholar] [CrossRef] [PubMed]
- Zhu, Y.-J.; Chen, F. Microwave-Assisted Preparation of Inorganic Nanostructures in Liquid Phase. Chem. Rev. 2014, 114, 6462–6555. [Google Scholar] [CrossRef]
- Rueden, C.T.; Schindelin, J.; Hiner, M.C.; DeZonia, B.E.; Walter, A.E.; Arena, E.T.; Eliceiri, K.W. ImageJ2: ImageJ for the next Generation of Scientific Image Data. BMC Bioinform. 2017, 18, 529. [Google Scholar] [CrossRef]
- Sánchez-Sánchez, R.; Brena-Molina, A.; Martínez-López, V.; Melgarejo-Ramírez, Y.; de Dios, L.T.; Gómez-García, R.; de Lourdes Reyes-Frías, M.; Rodríguez-Rodríguez, L.; Garciadiego-Cázares, D.; Lugo-Martínez, H.; et al. Generation of Two Biological Wound Dressings as a Potential Delivery System of Human Adipose-Derived Mesenchymal Stem Cells. ASAIO J. 2015, 61, 718–725. [Google Scholar] [CrossRef][Green Version]
- Orta-García, S.T.; Plascencia-Villa, G.; Ochoa-Martínez, A.C.; Ruiz-Vera, T.; Pérez-Vázquez, F.J.; Velázquez-Salazar, J.J.; Yacamán, M.J.; Navarro-Contreras, H.R.; Pérez-Maldonado, I.N. Analysis of Cytotoxic Effects of Silver Nanoclusters on Human Peripheral Blood Mononuclear Cells “in Vitro”. J. Appl. Toxicol. 2015, 35, 1189–1199. [Google Scholar] [CrossRef]
- Miles, A.A.; Misra, S.S.; Irwin, J.O. The Estimation of the Bactericidal Power of the Blood. J. Hyg. 1938, 38, 732–749. [Google Scholar] [CrossRef]

Publisher’s Note: MDPI stays neutral with regard to jurisdictional claims in published maps and institutional affiliations. |
© 2022 by the authors. Licensee MDPI, Basel, Switzerland. This article is an open access article distributed under the terms and conditions of the Creative Commons Attribution (CC BY) license (https://creativecommons.org/licenses/by/4.0/).
Share and Cite
Pérez-Díaz, M.A.; Alvarado-Gómez, E.; Martínez-Pardo, M.E.; José Yacamán, M.; Flores-Santos, A.; Sánchez-Sánchez, R.; Martínez-Gutiérrez, F.; Bach, H. Development of Radiosterilized Porcine Skin Electrosprayed with Silver Nanoparticles Prevents Infections in Deep Burns. Int. J. Mol. Sci. 2022, 23, 13910. https://doi.org/10.3390/ijms232213910
Pérez-Díaz MA, Alvarado-Gómez E, Martínez-Pardo ME, José Yacamán M, Flores-Santos A, Sánchez-Sánchez R, Martínez-Gutiérrez F, Bach H. Development of Radiosterilized Porcine Skin Electrosprayed with Silver Nanoparticles Prevents Infections in Deep Burns. International Journal of Molecular Sciences. 2022; 23(22):13910. https://doi.org/10.3390/ijms232213910
Chicago/Turabian StylePérez-Díaz, Mario Alberto, Elizabeth Alvarado-Gómez, María Esther Martínez-Pardo, Miguel José Yacamán, Andrés Flores-Santos, Roberto Sánchez-Sánchez, Fidel Martínez-Gutiérrez, and Horacio Bach. 2022. "Development of Radiosterilized Porcine Skin Electrosprayed with Silver Nanoparticles Prevents Infections in Deep Burns" International Journal of Molecular Sciences 23, no. 22: 13910. https://doi.org/10.3390/ijms232213910
APA StylePérez-Díaz, M. A., Alvarado-Gómez, E., Martínez-Pardo, M. E., José Yacamán, M., Flores-Santos, A., Sánchez-Sánchez, R., Martínez-Gutiérrez, F., & Bach, H. (2022). Development of Radiosterilized Porcine Skin Electrosprayed with Silver Nanoparticles Prevents Infections in Deep Burns. International Journal of Molecular Sciences, 23(22), 13910. https://doi.org/10.3390/ijms232213910

